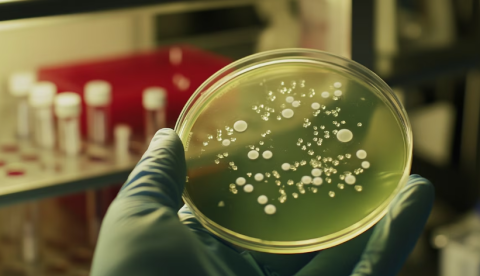

Los científicos del Imperial College de Londres pasaron una década investigando cómo las bacterias adquieren ADN y se vuelven más resistentes a los antibióticos. Luego, en una prueba con el sistema de inteligencia artificial de Google, el mismo problema se resolvió en solo 48 horas.
El sistema, llamado cocientífico, forma parte de los desarrollos de IA de la compañía y está diseñado para generar hipótesis científicas de manera autónoma.
Aunque no puede realizar experimentos, su capacidad para procesar datos y proponer teorías en cuestión de días podría transformar la forma en que se llevan a cabo las investigaciones biomédicas.
La prueba en Imperial College
El profesor José Penadés y su equipo en el Imperial College de Londres llevaban años estudiando cómo ciertas bacterias pueden acumular ADN de otros microorganismos y volverse más resistentes a los antibióticos, explicó en un artículo el medio británico The Telegraph.
Este proceso, clave en la resistencia a los antimicrobianos (RAM), se considera una de las principales amenazas para la salud global, con proyecciones de causar millones de muertes al año para 2050.
Después de años de trabajo, los investigadores lograron demostrar experimentalmente cómo las bacterias podían intercambiar material genético a través de cápsides, estructuras virales que transportan ADN. Y sus hallazgos fueron enviados para su publicación en la revista científica Cell.
Tras finalizar su estudio, el equipo de Imperial College decidió probar el cocientífico de Google para evaluar su capacidad. Introdujeron un par de oraciones describiendo el problema y esperaron su respuesta.
El papel de la IA de Google
En solo dos días, la inteligencia artificial generó su propia hipótesis sobre el fenómeno. Para sorpresa de los investigadores, su propuesta era exactamente la misma que ellos habían demostrado experimentalmente tras una década de trabajo.
“Fue la primera hipótesis que se planteó. Como podrán imaginar, fue bastante impactante”, afirmó Penadés a The Telegraph.
El Dr. Tiago Dias da Costa, experto en patogénesis bacteriana y coautor del estudio, destacó el impacto de este avance: “Son aproximadamente 10 años de investigación condensados en dos días por un cocientífico”.
A pesar de la velocidad y precisión de la IA, los científicos subrayaron que aún se necesitan experimentos para validar cualquier hipótesis. Sin embargo, su uso podría evitar años de trabajo fallido en los laboratorios.
“El sistema te da una respuesta y eso necesita ser validado experimentalmente. Pero el 90 por ciento de nuestros experimentos en el laboratorio son fallidos. Imaginen si tuviéramos un colaborador de IA que pudiera guiarnos para reducir los experimentos fallidos”, explicó el Dr. da Costa.
Reacciones y perspectivas
El impacto del cocientífico generó reacciones encontradas entre los investigadores. El profesor Penadés relató que recibió las hipótesis de la IA mientras estaba de compras y necesitó tiempo para procesar lo que había sucedido.
“Le dije a la persona que estaba conmigo que me dejara solo durante una hora para poder digerir esto”, le contó al medio británico.
“Una parte de mí pensaba que esto no podía ser verdad y que era asombroso, y la otra mitad lo encontraba muy aterrador”, afirmó.
Desde Google, el Dr. Alan Karthikesalingam, portavoz de la compañía, destacó el potencial de la IA en la investigación biomédica: “Pretende ser una herramienta de colaboración útil para los investigadores biomédicos y acelerar sus descubrimientos científicos”.
Además de la colaboración con el Imperial College, Google también probó la IA con investigadores de la Universidad de Stanford y el Instituto Metodista de Houston. En estos ensayos, la inteligencia artificial identificó posibles nuevos tratamientos para enfermedades, como la fibrosis hepática.
Otras pruebas y aplicaciones
El cocientífico de Google también mostró potencial en la investigación de nuevos medicamentos. En una de sus pruebas, sugirió que el fármaco Vorinostat, actualmente utilizado para tratar el cáncer de células inmunes, podría ser útil contra la fibrosis hepática, de acuerdo con The Telegraph.
Si bien aún es necesario realizar ensayos clínicos para confirmar esta hipótesis, el sistema demuestra cómo la IA puede acelerar el proceso de descubrimiento de tratamientos.
Además, la IA proporcionó explicaciones para misterios científicos no resueltos, incluyendo un enigma biológico que ha desconcertado a los investigadores durante 70 años. /Con información de Infobae-